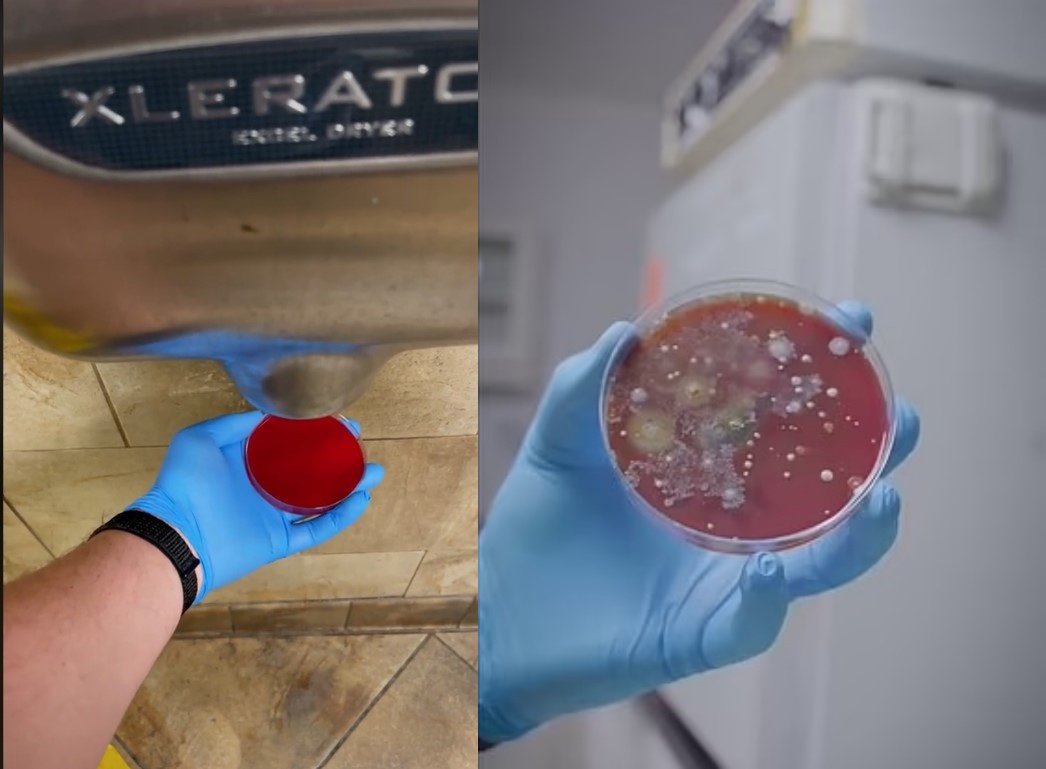

คลิปตรวจหาเชื้อโรคจากเครื่องเป่ามือในห้องน้ำ กลายเป็นไวรัลหลังพบเชื้อโรคเพียบ ด้านผู้เชี่ยวชาญเตือนควรหลีกเลี่ยง ใช้วิธีเช็ดมือหรือสะบัดให้แห้งดีกว่า
บัญชี TikTok @phonesoap ซึ่งเป็นบริษัทแห่งหนึ่งในสหรัฐอเมริกา ได้แชร์คลิปวิดีโอการตรวจหาเชื้อโรคจากเครื่องเป่ามือในห้องน้ำ เพื่อพิสูจน์ว่าการทำให้มือแห้งด้วยเครื่องเป่ามือจะมีเชื้อโรคมากแค่ไหน เมื่อเทียบกับการเช็ดมือด้วยกระดาษทิชชู่หรือปล่อยให้มือแห้งเอง

ในการทดสอบนี้ทาง phonesoap ได้เลือกเครื่องเป่ามือจาก 3 สถานที่ โดยใช้จานเพาะเชื้อรับลมจากเครื่องเป่ามือ และเปรียบเทียบกับการสะบัดเฉยๆ แทนการปล่อยให้มือแห้งเอง
จากผลทดสอบปรากฎว่า จานเพาะเชื้อที่สะบัดเฉยๆ ไม่มีอะไรเกิดขึ้นเลย ตรงข้ามกับจานเพาะเชื้อจากเครื่องเป่ามือที่มีเชื้อโรคเกิดขึ้น มากน้อยแตกต่างกันออกไป
จานเพาะเชื้อจากการสะบัดมือให้แห้ง

คลิปวิดีโอดังกล่าวกลายเป็นที่พูดถึงอย่างมาก มีผู้เข้าชมคลิปนี้มากกว่า 6.7 ล้านครั้ง นอกจากนี้นักระบาดวิทยาชื่อดังจากองค์การอนามัยโลก ดอกเตอร์ Feigl-Ding ยังได้แชร์คลิปวิดีโอดังกล่าวใน Twitter พร้อมเตือนว่า ไม่ควรใช้เครื่องเป่ามือหลังการล้างมือ ควรปล่อยสะบัดมือให้แห้งจะดีกว่า
ชมคลิปเต็มๆ ได้เลย
(คลิปไม่เล่นกดตรงนี้นะ)
@phonesoap How germy are hand air dryers…again?#PrimeDayDreamDeals #phonesoap ♬ original sound – PhoneSoap
ตามรายงานข่าวของ Daily Mail ก่อนหน้านี้นักวิจัยจากมหาวิทยาลัยลีด ในอังกฤษ ก็เคยออกมาเตือนเรื่องนี้เหมือนกัน โดยมีการเรียกร้องให้เลิกใช้เครื่องเป่ามือในห้องน้ำโรงพยาบาล เนื่องจากมันเป็นตัวกระจายเชื้อโรค อีกทั้งยังพบว่าเป็นแหล่งสะสมของแบคทีเรียที่อันตรายอีกด้วย
เรียบเรียงโดย #เหมียวเวจจี้